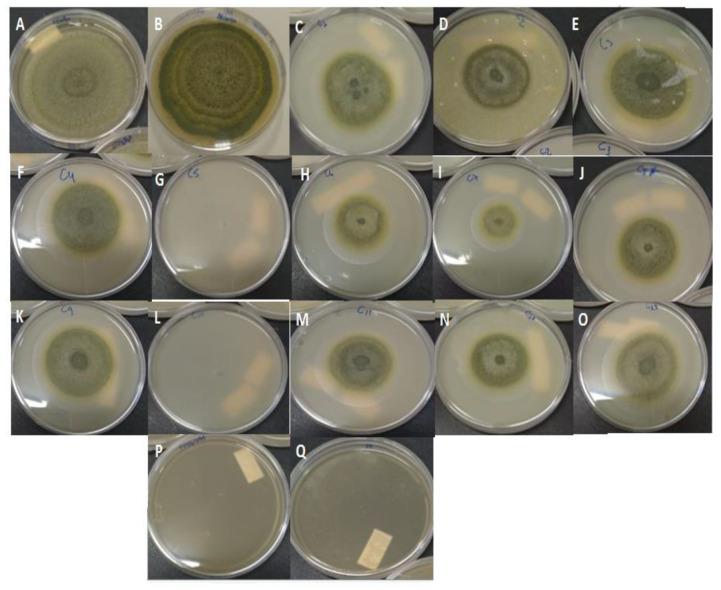
https://cdn.ncbi.nlm.nih.gov/pmc/blobs/0daf/8399424/ca2b356bf7c6/molecules-26-04825-g001.jpg

载有(玫瑰草)精油的纳米结构脂质载体的设计对抗 。
Design of Nanostructured Lipid Carriers Containing (Palmarosa) Essential Oil against .
机构信息
Department of Health Basic Sciences, State University of Maringá, Maringá 87020-900, PR, Brazil.
Department of Pharmacy, State University of Maringá, Maringá 87020-900, PR, Brazil.
出版信息
Molecules. 2021 Aug 10;26(16):4825. doi: 10.3390/molecules26164825.
Palmarosa essential oil (PEO) is an alternative to synthetic fungicides to control the contamination by food-deteriorating fungi, such as . Nonetheless, the low long-term stability and volatility hamper its utilization. Thus, this study aimed to develop nanostructured lipid carriers (NLCs) containing PEO to improve its stability and consequently prolong the activity against . A mixture design was applied to find the best preparation conditions for antifungal activity. The characterization analyses included size measurements, zeta potential (ζ-potential), entrapment efficiency (EE), and antifungal activity (by inhibition of mycelial growth (IMG) and/or in situ test (pre-contaminated Brazil nuts) tests). The nanocarriers presented particle sizes smaller than 300 nm, homogeneous size distribution, ζ-potential of -25.19 to -41.81 mV, and EE between 73.6 and 100%. The formulations F5 and F10 showed the highest IMG value (98.75%). Based on the regression model, three optimized formulations (OFs) were tested for antifungal activity (IMG and in situ test), which showed 100% of inhibition and prevented the deterioration of Brazil nuts by . The preliminary stability test showed the maintenance of antifungal activity and physicochemical characteristics for 90 days. These results suggest a promising system as a biofungicide against
香茅精油(PEO)是一种替代合成杀真菌剂的方法,可控制食品变质真菌的污染,如 。然而,其低长期稳定性和挥发性阻碍了其利用。因此,本研究旨在开发含有 PEO 的纳米结构化脂质载体(NLC),以提高其稳定性,从而延长其对 的活性。应用混合物设计来寻找最佳的制备条件以获得抗真菌活性。特征分析包括粒径测量、Zeta 电位(ζ-电位)、包封效率(EE)和抗真菌活性(通过抑制菌丝生长(IMG)和/或原位测试(预先污染的巴西坚果)测试)。纳米载体的粒径小于 300nm,粒径分布均匀,ζ-电位为-25.19 至-41.81mV,EE 为 73.6%至 100%。配方 F5 和 F10 表现出最高的 IMG 值(98.75%)。基于回归模型,对三种优化配方(OFs)进行了抗真菌活性(IMG 和原位测试)的测试,结果表明其抑制率达到 100%,并防止了巴西坚果的变质。初步稳定性测试表明,在 90 天内保持了抗真菌活性和物理化学特性。这些结果表明,该系统有望成为一种针对 的生物杀真菌剂。